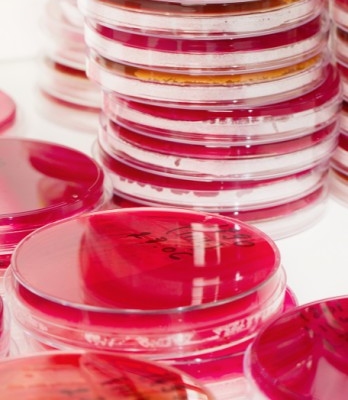

Výrobci potravin
- Telefon: +420 235 354 551
- E-mail: milcom@milcom-as.cz
- Adresa: Ke Dvoru 791/12a, Praha 6
Certifikát
ČSN EN ISO 9001:2016
Co nabízíme
Nabízíme kvalitní produkty a spolehlivé služby

Mlékárenské kultury
Mlékárenské kultury

Mikrobitesty a fosfatesty
Mikrobitesty a fosfatesty

Syřidla
Kvalitní syřidla a chlorid vápenatý pro domácí i komerční výrobu sýrů

Živné půdy
Živné půdy

Zkušební laboratoř
Zkušební laboratoř MILCOM a.s. VÚM č.1319

Sbírky CCDM a CCDBC
Sbírky CCDM Laktoflora® a CCDBC

Mezilaboratorní porovnání MPZ
Mezilaboratorní porovnání 2026

Školení a akce
Školení a akce

DEN VÚM 2026
Konference DEN VÚM 2026

Školení 2026
Školení 2026

Týden mléka 2026
Týden mléka 2026
Aktuality

 en
en